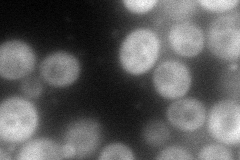
YPL110C
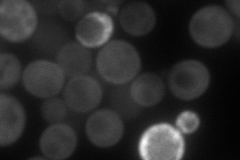
YPL110C
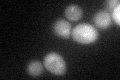
YPL110C

View description
Glycerophosphocholine (GroPCho) phosphodiesterase; hydrolyzes GroPCho to choline and glycerolphosphate, for use as a phosphate source and as a precursor for phosphocholine synthesis; may interact with ribosomes
Localization:
Intensity:
Fold change:
Significance:
-
C’ GFP library in SD

cytosol21.77 -
N' NOP1pr-GFP in SD
cytosol134.323 -
N' TEF2pr-mCherry in SD
cytosol,cell periphery111.501 -
N' NATIVEpr-GFP in SD

below threshold23.4028 -
N' TEF2pr-VC and Cyto-VN in SD

cytosol41.1697 -
C’ GFP library in SD+DTT
cytosol25.941.19No -
C’ GFP library in SD+H2O2

cytosol23.81.09No -
C’ GFP library in Starvation Media

cytosol19.790.9No -
C’ GFP library on the background of Pup2-DaMP

cytosol -
C’ GFP library on the background of CCT mutant

cytosol23.12941.06224No
